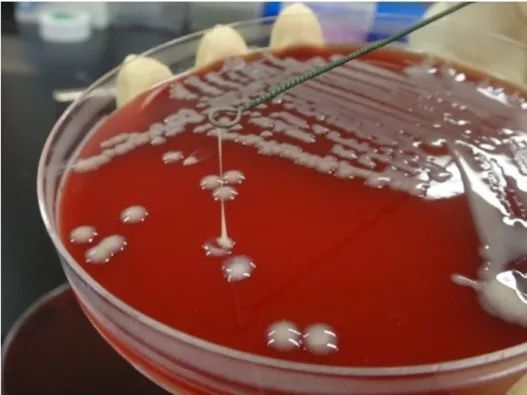
3.jpg 3.jpg

-
2024-8-13
嚙齒動(dòng)物血生化項目分析(下)
-
2024-8-6
小二麻痹癥與百萬(wàn)只猴
-
2024-7-30
非人靈長(cháng)類(lèi)動(dòng)物源的傳染病
-
2024-7-23
實(shí)驗動(dòng)物術(shù)后監測及切口閉合的原則
-
2024-7-16
獸醫流行病學(xué)在規模化猴場(chǎng)疾病防控中的應用
-
2024-7-9
嚙齒動(dòng)物血生化項目分析(上)
-
2024-7-2
實(shí)驗嚙齒動(dòng)物手術(shù)操作的止痛方案考量
-
2024-6-25
混亂的圈養食蟹猴遺傳組成
-
2024-6-18
規模化猴場(chǎng)傳染性疾病防控設想
-
2024-6-11
小鼠肺部插管簡(jiǎn)易方法
狨猴常見(jiàn)傳染性疾病
普通狨猴(Callithrix jacchus,下文簡(jiǎn)稱(chēng)絨猴)屬于狨科狨屬,是一種小型新大陸非人靈長(cháng)類(lèi)動(dòng)物,原產(chǎn)于巴西東部,自20世紀60年代初以來(lái)一直用于生物醫學(xué)研究,特別是在神經(jīng)科學(xué)研究、基因編輯、肥胖和代謝、傳染病、自身免疫性疾病和衰老等研究項目中作用被廣泛使用。和其它新大陸猴一樣,狨猴與舊大陸猴在生理、疾病易感性、飲食需求等多個(gè)方面都存在獨特的差異。目前,在我國現行標準和規范中,所提及的基本的飼養要求、獸醫護理、微生物控制要求和實(shí)驗技術(shù)主要是針對食蟹猴和恒河猴,對新大陸猴尚缺乏相關(guān)共識,在對實(shí)驗用狨猴進(jìn)行微生物質(zhì)量監測和控制時(shí),往往套用實(shí)驗獼猴的標準,導致狨猴實(shí)際易感的病原體被忽視,無(wú)益于狨猴質(zhì)量提升。本公眾號此前曾就狨猴的飼養、繁育和獸醫照護及其應用發(fā)表過(guò)兩篇推文(詳見(jiàn)《小身材,大用途!》和《狨猴飼養、繁育和獸醫照護》),本文將就常見(jiàn)的感染狨猴的病原體做簡(jiǎn)單介紹。

(供圖:江蘇靈賦兆生源)
病 毒
目前有報道的可自然感染狨猴的病毒有近二十種,其中比較重要和常見(jiàn)的有以下幾種:
皰疹病毒:
皰疹病毒科是一類(lèi)具有復雜基因組的包膜DNA病毒,根據基因組、宿主細胞和所致疾病,這些病原體被分為三個(gè)亞科:α皰疹病毒、β皰疹病毒和γ皰疹病毒。其中α皰疹病毒和γ皰疹病毒對狨猴而言更重要,它們通常對天然宿主有高度的適應,感染后表現為無(wú)癥狀或輕微癥狀的持續感染,而在發(fā)生跨物種傳播后,卻能夠引起嚴重的疾病和病理變化。
現已證明兩種α皰疹病毒可引起狨猴的嚴重疾病并在24-72小時(shí)內死亡,即源自人的單純皰疹病毒1型(HSV-1)和源自松鼠猴的Herpesvirus tamarinus。狨猴感染后通常有7 - 10天的潛伏期,然后出現發(fā)燒、嗜睡等非特異性臨床癥狀,隨著(zhù)病情的發(fā)展,出現結膜炎和唾液分泌過(guò)多,并在口腔黏膜上看到融合的囊泡,動(dòng)物死亡前則可出現神經(jīng)系統癥狀,例如共濟失調、上升性麻痹、失明和癲癇等。

狨猴感染HSV-1后眼周、面部、下唇、下巴出現紅斑和潰瘍
Edwards E. E. (2018)
可感染狨猴并誘發(fā)疾病的γ皰疹病毒有來(lái)源于松鼠猴的松鼠猴皰疹病毒(Herpesvirus saimiri,HVS)、來(lái)源于蜘蛛猴的Herpesvirus ateles和來(lái)源于人類(lèi)的EB病毒(Epstein-Barr virus,EBV),盡管人工感染狨猴后可出現淋巴增生性疾病、單核細胞增多癥等,但總體而言這幾種病毒的自然感染是很少見(jiàn)的。
預防這類(lèi)跨物種感染的關(guān)鍵是將不同種類(lèi)的動(dòng)物單獨飼養,杜絕與其它NHP和狨猴共享飼養空間和可能被污染的物品,人員也應做好防護,避免交叉感染。
此外,近些年一種新的淋巴隱潛病毒CalHV-3(Callitrichine Herpesvirus 3)被從狨猴惡性淋巴瘤中檢測到,盡管大多數動(dòng)物感染后沒(méi)有明顯臨床癥狀,但會(huì )有一些動(dòng)物表現為體重減輕、食欲不振、腹瀉和腹部腫塊。這種γ皰疹病毒已在多個(gè)狨猴群體中被發(fā)現,血清學(xué)調查則顯示人工圈養狨猴中有40%至60%的陽(yáng)性率。
淋巴細胞脈絡(luò )叢腦膜炎病毒(LCMV):
LCMV 感染可導致狨猴肝炎,具有高發(fā)病率和高死亡率的特點(diǎn)。狨猴通過(guò)接觸攜帶病毒的野生小鼠而被感染,臨床癥狀在一至兩周內出現,包括呼吸困難、厭食、虛弱和嗜睡。受感染的動(dòng)物可出現肝功能衰竭的癥狀,包括黃疸和凝血功能障礙。可能在無(wú)臨床癥狀的情況下發(fā)生猝死。可觀(guān)察到膽紅素、血清堿性磷酸酶和谷丙轉氨酶值升高。在沒(méi)有臨床疾病體征的狨猴中,LCMV感染的血清學(xué)證據也已被證實(shí)。應通過(guò)控制野生嚙齒動(dòng)物和篩選食物來(lái)源預防,如果在狨猴中使用鼠源性生物制劑,則應檢測確認其是否攜帶LCMV。
副流感病毒:
副流感病毒1型(猴病毒5)、2型(猴病毒41)和3型(猴病毒10)與新世界靈長(cháng)類(lèi)動(dòng)物的疾病有關(guān)。由于這些病毒缺乏種屬特異性,狨猴的感染可能是在擁擠和應激條件下由人類(lèi)或其他物種傳播而來(lái),可通過(guò)直接接觸或空氣傳播。
與副流感病毒相關(guān)的臨床疾病可能從輕度上呼吸道疾病癥狀到嚴重的鼻氣管支氣管炎和間質(zhì)性肺炎不等。該病的臨床癥狀可能包括打噴嚏、眼分泌物和鼻分泌物、咳嗽、呼吸困難和厭食。一歲以下的動(dòng)物病情可能更為嚴重。在大多數情況下,動(dòng)物會(huì )自發(fā)地從自然感染中恢復。治療在很大程度上是支持性的,旨在最大限度地降低細菌繼發(fā)感染的風(fēng)險。
麻疹病毒:
從歷史上看,麻疹病毒曾經(jīng)造成非人類(lèi)靈長(cháng)類(lèi)動(dòng)物的常見(jiàn)和廣泛的感染,并可造成極高發(fā)病率和死亡率。非人靈長(cháng)類(lèi)動(dòng)物的麻疹病毒感染通常是通過(guò)與感染的人類(lèi)接觸而引發(fā)的。
在狨猴中,通常沒(méi)有在舊大陸猴中常見(jiàn)的特征性的皮疹,而是以血性腹瀉為主要癥狀,隨后出現體溫過(guò)低、眼眶周?chē)[、心血管衰竭和死亡。出現并發(fā)感染的動(dòng)物病情可能更為嚴重,死亡率可能接近100%。
目前尚無(wú)有效的麻疹病毒感染治療方法,接種人減毒疫苗是安全且有保護作用的,可以考慮用于群體免疫。對于繼發(fā)性細菌感染,經(jīng)驗性和支持性治療,如補液、補充熱量和抗生素可能是有益的。
細 菌
和病毒感染一樣,狨猴易感的細菌和獼猴也有明顯異同,最顯著(zhù)的差異是新大陸猴對結核分枝桿菌的敏感性明顯要低,少見(jiàn)狨猴自然發(fā)生結核病的案例。盡管少見(jiàn),但鑒于結核對人類(lèi)和獼猴的重要影響,還是需要定期對狨猴進(jìn)行檢測。相較于獼猴,在狨猴群體中另一些細菌有更高的發(fā)生率和致病性,例如肺炎克雷伯桿菌和鮑特氏菌。
支氣管鮑特氏菌:
支氣管鮑特氏菌可通過(guò)氣溶膠飛沫傳播,因此可在狨猴群體中迅速擴散。常見(jiàn)的第一個(gè)臨床癥狀是雙側粘液膿性鼻涕,其他體征包括發(fā)熱和呼吸困難。一歲以下的動(dòng)物更有可能突然病重和死亡。在許多情況下,動(dòng)物死亡之前甚至沒(méi)有表現出任何異常。
用土霉素治療可以預防成年動(dòng)物死亡,并降低青年動(dòng)物死亡率。
肺炎克雷伯桿菌:
肺炎克雷伯桿菌常存在于人的鼻咽部和胃腸道中,也是醫院常見(jiàn)的院內感染菌。從野外捕獲的狨猴群,以及有大量寄生蟲(chóng)負擔的衰弱動(dòng)物中,往往更容易爆發(fā)克雷伯桿菌感染。肺炎克雷伯菌感染可導致狨猴發(fā)生彌漫性腸炎和/或肺炎,并導致動(dòng)物死亡。臨床癥狀包括腹瀉和體溫過(guò)低等。有報道稱(chēng)年幼的動(dòng)物更容易受到感染,死亡率可高達13%,甚至許多動(dòng)物未出現臨床癥狀就已經(jīng)死亡。
可以嘗試使用抗生素,但治療效果往往不佳,主要由于肺炎克雷伯桿菌往往有多重耐藥性。克雷伯桿菌可能在設施中定植,并且難以通過(guò)現有的標準衛生程序和滅菌技術(shù)來(lái)消除。
肺炎克雷伯桿菌的菌落特征,粘稠拉絲
K.Kazufumi (2017)
腸致病性大腸桿菌(EPEC):
盡管大多數攜帶該菌的動(dòng)物都是無(wú)癥狀的,但EPEC也經(jīng)常導致狨猴腹瀉。該菌通過(guò)糞-口途徑傳播。
在狨猴中,臨床疾病通常以急性出血性腹瀉為特征,但也可能表現為慢性進(jìn)行性腹瀉。嚴重的臨床疾病可伴有嗜中性粒細胞增多,盡管失血,但通常不會(huì )出現貧血。
恩諾沙星劑量5mg /kg體重,每天口服一次,是治療EPEC的一種非常有效的方法。盡管對單個(gè)動(dòng)物進(jìn)行了有效的治療,但該菌可能會(huì )在猴群中持續存在。
寄 生 蟲(chóng)
新進(jìn)口野外捕獲的的狨猴群體中,寄生蟲(chóng)病常導致動(dòng)物大量發(fā)病和死亡,而人工圈養種群中發(fā)生這種情況的風(fēng)險則很小,更常見(jiàn)的是亞臨床寄生,僅在應激或實(shí)驗操作中表現出臨床癥狀。糞類(lèi)圓線(xiàn)蟲(chóng)和賈第鞭毛蟲(chóng)可能在一些狨猴群體中很常見(jiàn),但在營(yíng)養和飼養管理良好的動(dòng)物中很少致病。
賈第鞭毛蟲(chóng):
賈第鞭毛蟲(chóng)分布廣泛,可感染人類(lèi)和多種非人靈長(cháng)類(lèi)動(dòng)物,包括狨猴。它們的生命周期包括兩個(gè)階段:滋養體和包囊,其中包囊具有傳染性,且有一定環(huán)境抗性。
感染賈第鞭毛蟲(chóng)的動(dòng)物會(huì )間歇性地排出包囊,并通過(guò)糞-口途徑傳播。感染賈第鞭毛蟲(chóng)的狨猴尚未有致病的報道,但在其他新大陸猴中,報道的癥狀包括血性或非血性腹瀉,直腸脫垂,嗜睡,脫水等。
賈第鞭毛蟲(chóng)病的治療方法是口服甲硝唑,劑量為30-50 mg/kg,連續用藥5到10天。
小隱孢子蟲(chóng):
小隱孢子蟲(chóng)是體積微小的胞內機會(huì )致病性原蟲(chóng),可感染多種脊椎動(dòng)物,包括人。感染的動(dòng)物糞便中含有大量有傳染性的卵囊,其對常見(jiàn)的水消毒技術(shù)有抗性,例如氯化、次氯酸鈉處理和過(guò)濾。小隱孢子蟲(chóng)通過(guò)糞-口途徑傳播,可能的感染源包括污染的水、帶蟲(chóng)的動(dòng)物、污染的物品等。此外,蟑螂和家蠅也被認為是潛在媒介。
這種原蟲(chóng)所致的疾病被稱(chēng)為隱孢子蟲(chóng)病,在免疫功能正常的狨猴群中可能是自限性的,感染的臨床癥狀最可能出現在免疫功能低下的動(dòng)物和新生動(dòng)物身上,常見(jiàn)癥狀包括大量水樣腹瀉和脫水。
隱孢子蟲(chóng)病沒(méi)有可靠和有效的治療方法,通常只能采取支持性治療。
弓形蟲(chóng):
剛地弓形蟲(chóng)是一種在全世界都有廣泛分布的原蟲(chóng),狨猴特別容易感染,且在大多數情況下會(huì )導致死亡。最有可能的感染源是帶有卵囊的貓科動(dòng)物或其它動(dòng)物的糞便。狨猴感染的臨床癥狀在接觸傳染源后3至5天出現,包括虛弱、呼吸窘迫,隨后在1至7天內死亡。此外還可能出現厭食、嗜睡、咳嗽、眼分泌物和鼻分泌物。與狨猴相比,其他新大陸猴可能更具抵抗力。
由于這種疾病進(jìn)展迅速,血清學(xué)檢測對狨猴的價(jià)值通常有限。對發(fā)病動(dòng)物,尸檢結果與組織學(xué)檢查相結合是診斷的主要方法。主要的控制方法是盡量減少接觸貓和其它動(dòng)物的糞便。
磺胺嘧啶和乙胺嘧啶是最常見(jiàn)的兩種用于治療弓形蟲(chóng)病的藥物。
Trichospirura leptostoma:
Trichospirura leptostoma是一種螺旋尾線(xiàn)蟲(chóng),1967年首次被報道,寄生在狨猴和其他新大陸猴的胰管中,在新捕獲的動(dòng)物中較為常見(jiàn)。可引起慢性胰腺炎,導致亞臨床到臨床胰腺功能不全和繼發(fā)性營(yíng)養不良。受影響的狨猴體重減輕,糞便量增加,肌肉無(wú)力,乃至后肢輕度癱瘓,新生動(dòng)物死亡率增加。實(shí)驗感染后8至9周,狨猴糞便中可檢測到卵,蟲(chóng)卵脫落可長(cháng)達兩年。
推薦治療藥物為芬苯達唑,劑量為50mg/kg,持續14天。在動(dòng)物設施中盡量減少中間宿主德國小蠊和長(cháng)翅超蠊的數量可有效控制其擴散。
Prosthenorchis elegant:
Prosthenorchis elegant是棘頭蟲(chóng)前睪屬的一種寄生蟲(chóng),其感染新大陸猴的報道非常常見(jiàn),這種寄生蟲(chóng)可附著(zhù)在動(dòng)物回腸、盲腸和結腸粘膜表面。常見(jiàn)的臨床癥狀包括腹瀉、厭食和腹脹。其吻鉤可穿透粘膜表面,引起嚴重的肉芽腫性炎癥反應,若穿透漿膜表面則可能繼發(fā)性膿毒性腹膜炎,并常導致急性死亡。目前還沒(méi)有有效的治療方法,控制措施必須針對性消滅作為中間宿主的蟑螂、甲蟲(chóng)。

Prosthenorchis elegant的電鏡照片
Rojas-Sánchez, E.(2023)
由于狨猴易感的病原體種類(lèi)不同于獼猴,應針對性制定適合狨猴的健康監測方案和微生物質(zhì)量控制要求,以便更有效提升狨猴的健康水平和研究數據的可靠性。
參考文獻:
1. Ludlage E, Mansfield K. Clinical care and diseases of the common marmoset (Callithrix jacchus). Comp Med. 2003 Aug;53(4):369-82. PMID: 14524413.
2. Edwards, E. E., Birch, S. M., Hoppes, S. M., Keating, M. K., & Stoica, G. (2018). Pathology in Practice. Journal of the American Veterinary Medical Association, 253(4), 423-426.
3. Fitz C, Goodroe A, Wierenga L, Mejia A, Simmons H. Clinical Management of Gastrointestinal Disease in the Common Marmoset (Callithrix jacchus). ILAR J. 2020 Dec 31;61(2-3):199-217. doi: 10.1093/ilar/ilab012. PMID: 33989417; PMCID: PMC9214573.
4. Rojas-Sánchez E, Uma?a-Blanco F, Jiménez-Rocha A, Vega-Benavides K, Medaglia A, Solano-Barquero A, Rojas A, Jiménez M. Cryptic diversity in a gastrointestinal acanthocephalan of New World primates from Costa Rica. Sci Rep. 2023 Feb 10;13(1):2402. doi: 10.1038/s41598-023-28585-1. PMID: 36765145; PMCID: PMC9918474.


